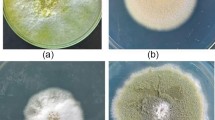

Abstract
Biorefineries are core facilities for implementing a sustainable circular bioeconomy. These facilities rely on microbial enzymes to hydrolyze lignocellulosic substrates into fermentable sugars. Fungal co-cultures mimic the process of natural biodegradation and have been shown to increase certain enzyme activities. Trichoderma reesei and its many mutant strains are major cellulase producers and are heavily utilized as a source of carbohydrate-active enzymes. Several reports have demonstrated that T. reesei co-cultures present higher enzyme activities compared with its monocultures, especially in the context of β-glucosidase activity. The performance of T. reesei during co-culturing has been assessed with several fungal partners, including Aspergillus niger, one of the most recurrent partners. Various aspects of co-cultivation still need further investigation, especially regarding the molecular interactions between fungi in controlled environments and the optimization of the resulting enzyme cocktails. Since plenty of genetic and physiological data on T. reesei is available, the species is an outstanding candidate for future co-culture investigations. Co-cultures are still a developing field for industrial enzyme production, and many aspects of the technique need further improvement before real applications.
Key points
• T. reesei co-cultures are an alternative for producing lignocellulolytic enzymes.
• Several reports suggest an increase in certain enzyme activities in co-cultures.
• More in-depth investigations of co-cultures are necessary for advancing this field.
Similar content being viewed by others
Avoid common mistakes on your manuscript.
Introduction
As awareness of environmental problems caused by the linear fossil-based economy grows, society is slowly moving towards a more circular bioeconomy. Lignocellulosic biorefineries are core facilities for this new model, utilizing lignocellulosic residues to produce new biotechnological products in a sustainable manner (Silva et al. 2017). Biorefineries rely on enzymes to decompose plant residues into fermentable sugars. Such enzymes generally come from microbial sources, such as bacteria and fungi (Adrio and Demain 2014). The fungus Trichoderma reesei is a major workhorse in the carbohydrate-active enzyme industry. The industrial strain T. reesei RUT-C30 is utilized for its outstanding production of cellulases, sometimes yielding approximately 100 g L−1 of protein in submerged cultures (Bischof et al. 2016).
Cellulases are a generic denomination for enzymes specialized in deconstructing cellulose, the major component of plant cell walls, and thus, the major component of lignocellulosic feedstocks (LCFs). These lignocellulosic materials are the most suitable substitutes for fossil fuels because of their versatility and sustainability. A great challenge in the new bioeconomy is the conversion of lignocellulosic biomass into fermentable sugars, which in turn can be converted into biofuels and other bioproducts. This objective is, however, often hindered by the cost of the enzymes.
Not even T. reesei and its many mutant strains are perfect cellulose degraders. It is well known that the production of β-glucosidase, the enzyme responsible for hydrolyzing cellobiose into two glucose monomers, is low in this fungus (Bischof et al. 2016; Grous et al. 1985; Okeke 2014). The imbalance between β-glucosidase and the other cellulases creates a bottleneck at the end of the hydrolysis chain due to feedback inhibition of cellobiose over other cellulases (Sørensen et al. 2013).
Several approaches can be employed to improve enzyme cocktails. At the strain level, modifications, such as random mutagenesis (Bischof et al. 2016) and genetic engineering (Chen et al. 2020), have been employed to improve T. reesei enzyme expression. The carbon source can also be modified by pre-treatment (Kumar and Sharma 2017) and liquefaction (Cunha et al. 2014) techniques, increasing the enzyme production and improving enzymatic access to the substrate.
Another alternative for improving enzyme cocktails is to cultivate two or more fungi with complementary enzyme activities to create a more diverse and robust enzyme pool. This technique is referred to as a co-culture. There are still very few investigations addressing fungal co-cultures; some of them show promising results. In this review, co-cultures of T. reesei, the major cellulase producer, have been discussed, highlighting culture partners, major findings, and future challenges of this largely unmapped field.
Lignocellulose degradation and co-cultures
Lignocellulose is a complex network of carbohydrates and lignin and is composed of three major components: cellulose, hemicellulose, and lignin. Cellulose is composed of glucose monomers linked together by linear β-1,6 glycosidic bonds (Cosgrove 2014). Hemicellulose is a heterogeneous compound with a myriad of carbohydrate polymers, such as xylans, xyloglucans, and mannan (Moreira and Filho 2008; Scheller and Ulvskov 2010). Lignin is a complex polyphenolic network and is one of the major causes of recalcitrance of the plant cell wall owing to its non-repetitive structure (Espiñeira et al. 2011). Further, the presence of pectin, a gel-like structure composed of galacturonic acid polymers, helps keep all the aforementioned constituents together (Daher and Braybrook 2015). Due to its complexity, lignocellulose degradation is not efficiently accomplished by a single organism in nature. It is actually a long process involving many organisms across space and time. Different microorganisms are specialized in degrading different portions of the lignocellulosic material. For example, T. reesei is a good cellulose degrader, but lacks enzymes responsible for lignin degradation, which are present in white rot fungi (Kong et al. 2017).
Saprophytic fungi compete over space in decaying lignocellulosic substrates when multiple species are present simultaneously. While doing so, they employ several strategies, such as secretion of inhibitory volatile and diffusible organic compounds (Hiscox et al. 2018; Siddiquee 2014), to outcompete other fungi (Fig. 1). They may also increase the expression of oxidative stress-related (Igarashi et al. 2018; Ujor et al. 2018), lignin-modifying, and carbohydrate-active (Igarashi et al. 2018) enzymes. The latter strategy is of special biotechnological interest, since it could potentially improve the production of commercially important enzymes.
a A hypothetical fungal interaction between Trichoderma reesei (green) and another fungus on a decaying tree trunk. During fungal interactions, the participants secrete a myriad of diffusible and volatile organic compounds (DOCs and VOCs, respectively) in order to outcompete the other species. The fungi also secrete more enzymes to better utilize the available substrate and harvest sugars to fuel their growth and combative metabolism. b The combination of fungal enzymes achieves a more complete degradation of the lignocellulosic substrate. Green and red geometric shapes represent T. reesei and other fungal enzymes, respectively, acting on lignocellulosic fibers. Empty circles represent the carbohydrate portion, whereas the brown straight line represents lignin
Since lignocellulosic degradation is a slow process, different species of fungi can colonize the same material over time. In such cases, the first colonizer modifies the substrate, creating either a suitable or an inhibitory environment for other species (Ottosson et al. 2014). This relationship creates a succession of different species over time on the same lignocellulosic substrate, depending on the microbial community present (Ottosson et al. 2014).
As stated, nature rarely utilizes a single organism to perform a certain task. This concept of co-culturing a microbial consortium can be applied to industrial microbiology and is already being used in the food and beverage industry (Bokulich et al. 2014; Hymery et al. 2014). It can also be applied to the production of lignocellulosic enzymes by co-culturing more than one fungus to obtain enzyme cocktails that differ from their monoculture counterparts (Sperandio and Filho 2019).
T. reesei and its co-cultures with Aspergillus niger
T. reesei was first isolated during World War II as a fungus known to degrade US military equipment in the South Pacific (Do Vale et al. 2014). The first strain was denominated as “QM6a,” and all the hypercellulolytic mutants available today are derived from it (Bischof et al. 2016). Currently, the mutant T. reesei RUT-C30 is the standard strain used for cellulase production.
T. reesei is a reasonable choice for using in a co-culture. It has an outstanding ability to produce cellulases and has a low β-glucosidase activity (BGA), the disadvantage that has to be mitigated (Rana et al. 2014). Among the studies already conducted with T. reesei, one of the most common partners in the co-culture is A. niger.
A. niger is an ascomycete belonging to the black Aspergilli group (Abarca et al. 2004). This species is commonly found in soil and is also a frequent food contaminant (D’hooge et al. 2019). A. niger has a worldwide distribution, and some specimens have even been isolated from the International Space Station (Abarca et al. 2004; Romsdahl et al. 2018). Several industrial applications, such as the production of organic acids, foods, pharmaceuticals, and enzymes, rely on A. niger strains (Abarca et al. 2004; D’hooge et al. 2019; Papagianni 2007), many of which possess the Generally Regarded As Safe (GRAS) title.
A. niger is a rational co-culture choice for T. reesei considering its secretion of β-glucosidases (Ahamed and Vermette 2008; van Munster et al. 2014). Theoretically, A. niger could provide the final enzyme cocktail with higher BGA, while avoiding many other costs, such as double fermentation structure, downstream processing of enzymes, and mixing of two independent cocktails. Many positive results in this regard have already been obtained and have been compiled in Table 1. However, loss in the activity of certain enzymes, such as reduction in endoglucanase activity (EGA) by 49% (Rabello et al. 2014) and 30% (Kolasa et al. 2014), has also been reported.
Reduction in the activity of certain enzymes is one of the known challenges of co-cultivation. This can occur due to different culture conditions that may not be suitable for all the organisms involved. In the T. reesei/A. niger co-culture, the latter strongly acidifies the medium when inoculated before the former, thus, creating suboptimal conditions for the former (Maheshwari et al. 1994). To better understand such relationships, studies regarding the order and ratios of inoculation for each participant are extremely relevant (Kolasa et al. 2014; Ma and Ruan 2015).
Results of co-cultures may vary greatly even when the same species are utilized, as can be seen in Table 1. In case of A. niger, apart from the culture conditions, one of the possible factors contributing to this variation is the misidentification of the microorganism. Many Aspergilli in the section Nigri are morphologically similar; thus, solely relying on morphological identification can be misleading (D’hooge et al. 2019). Molecular identification of strains is highly recommended, when possible, to confirm the identity of A. niger.
Proteomic analysis is another crucial tool to understand the interaction between A. niger and T. reesei. Florencio et al. (2016) investigated the secretome of both fungi and monocultures, under submerged and sequential cultivation, using sugarcane bagasse as a carbon source. They found that only 27% and 29% of total proteins are common between the two cultivation methods for T. reesei and A. niger, respectively. If changing the cultivation method has such an impact on the secretome content, it is very likely that co-cultivation will also have the same impact. The secretome of both fungi has been studied elsewhere (Borin et al. 2015; di Cologna et al. 2018), but never as co-cultures. The data already available for A. niger and T. reesei secretomes will undoubtedly facilitate future comparisons, once co-culture studies of this nature are published.
T. reesei co-cultures with other fungi
Apart from A. niger, other Aspergilli have been co-cultured with T. reesei. Brijwani et al. (2010) co-cultured T. reesei with A. oryzae using solid-state fermentation (SsF), with soybean hulls and wheat bran as carbon sources. They obtained a 64.6% increase in filter paper activity (FPA) and a 70% higher BGA in comparison to T. reesei monocultures. Kolasa et al. (2014) found an impressive increase of more than 1000% in BGA upon co-cultivating T. reesei RUT-C30 and A. saccharolyticus under SsF, with wheat bran as the carbon source. Influence of the order of inoculation of the participants on the final enzyme activity was also observed in the study. Simultaneous inoculation of both T. reesei RUT-C30 and A. saccharolyticus resulted in an almost 2-fold increase in BGA compared to cultures with a 48-h delay in Aspergillus inoculation. However, for EGA, the same 48-h delay yielded almost three times better results. Findings of the aforementioned studies and more examples of co-cultures between T. reesei and other fungi have been compiled in Table 2.
Cases where the monocultures performed better than their co-cultures have also been reported. Campioni et al. (2020) co-cultured T. reesei QM 9414 with T. harzianum and two strains of A. fumigatus in submerged fermentation (SmF), using sugarcane straw as the carbon source, and all combinations had lower xylanase and cellulase activities compared to T. reesei QM 9414 cultured alone (Table 2). T. reesei QM 9414 and A. fumigatus M51 co-culture resulted in 90% and 33% reduction in FPA and xylanase activity, respectively, compared to the monoculture of the former (Campioni et al. 2020).
Another recurrent strategy is to co-culture T. reesei strains with white-rot fungi, basidiomycetes capable of secreting lignin-degrading enzymes (Alfaro et al. 2014). As a defense mechanism, white-rot fungi can secrete more lignin-degrading enzymes, such as laccases and manganese peroxidase, when cultivated with other fungi compared to their monocultures (Igarashi et al. 2018; Mali et al. 2017). Mixing the capacity to produce such enzymes with the cellulolytic capabilities of T. reesei could, theoretically, create an enzyme cocktail that fully degrades all lignocellulose components. Yang et al. (2013) co-cultured T. reesei RUT-C30 with Phanerochaete chrysosporium, a white-rot fungus, under SmF, utilizing pumpkin residues as the carbon source. The study reported an increase in the activity of all carbohydrate-active enzymes analyzed in the co-culture compared to T. reesei monoculture, as well as higher lignin-degrading activities compared to P. chrysosporium monoculture (Table 2).
As reported by Ma and Ruan (2015), co-cultivation of T. reesei with Coprinus comatus under SmF, with a complex lignocellulosic mixture as the carbon source (Table 2), resulted in the same EGA as T. reesei alone. There was also a 44% decrease in xylanase activity compared to T. reesei monocultures. However, this co-culture achieved a 21% increase in laccase activity in relation to C. comatus monoculture.
Conclusion
Natural biodegradation of lignocellulosic residues is achieved in nature by microbial co-cultures. From a biotechnological perspective, T. reesei co-cultures with both A. niger and other fungi have shown an improvement in the activity of certain enzymes, especially β-glucosidase, which T. reesei is deficient in. Thus, the technique is a promising alternative for producing new enzymatic cocktails for biorefineries, expanding the frontiers of the new bioeconomy.
To date, co-culturing is a trial-and-error exercise, with limited predictability. Lack of information about the molecular interactions between the participants hinders any rational design of co-cultures. This is a challenge for all co-cultures, and not just for those utilizing T. reesei. Future studies must focus on utilizing omics approaches to unveil the molecular interactions between fungi in industrial cultivation environments. In addition, the evaluation of co-cultures in large-scale experiments is necessary before this technique can be effectively employed in real biorefineries.
Co-culturing filamentous fungi for enzyme production still poses many challenges and unanswered questions that must be addressed in order to fully harness the potential of this technique. It is very likely that major advances in co-cultures, especially those utilizing T. reesei, will be achieved in the coming years. Co-cultures show promising results as an inexpensive and effortless way of obtaining enzymes and should be further investigated as a new source of enzymes for biorefineries.
References
Abarca ML, Accensi F, Cano J, Cabañes F (2004) Taxonomy and significance of black aspergilli. Antonie Van Leeuwenhoek 86:33–49
Adrio JL, Demain AL (2014) Microbial enzymes: tools for biotechnological processes. Biomol 4:117–139. https://doi.org/10.3390/biom4010117
Ahamed A, Vermette P (2008) Enhanced enzyme production from mixed cultures of Trichoderma reesei RUT-C30 and Aspergillus niger LMA grown as fed batch in a stirred tank bioreactor. Biochem Eng J 42:41–46. https://doi.org/10.1016/j.bej.2008.05.007
Alfaro M, Oguiza JA, Ramírez L, Pisabarro AG (2014) Comparative analysis of secretomes in basidiomycete fungi. J Proteom 102:28–43. https://doi.org/10.1016/j.jprot.2014.03.001
Bischof RH, Ramoni J, Seiboth B (2016) Cellulases and beyond: the first 70 years of the enzyme producer Trichoderma reesei. Microb Cell Fact 15:106. https://doi.org/10.1186/s12934-016-0507-6
Bokulich NA, Ohta M, Lee M, Mills DA (2014) Indigenous bacteria and fungi drive traditional kimoto sake fermentations. Appl Environ Microbiol 80:5522–5529. https://doi.org/10.1128/AEM.00663-14
Borin GP, Sanchez CC, De Souza AP, De Santana ES, De Souza AT, Leme AFP, Squina FM, Buckeridge M, Goldman GH, De Castro Oliveira JV (2015) Comparative secretome analysis of Trichoderma reesei and Aspergillus niger during growth on sugarcane biomass. PLoS One 10:1–20. https://doi.org/10.1371/journal.pone.0129275
Brijwani K, Oberoi HS, Vadlani PV (2010) Production of a cellulolytic enzyme system in mixed-culture solid-state fermentation of soybean hulls supplemented with wheat bran. Process Biochem 45:120–128. https://doi.org/10.1016/j.procbio.2009.08.015
Campioni TS, Carvalho AFA, Figueiredo FC, Silva DF, Neto PO (2020) Xylanases and cellulases biosynthesis by selected fungi in a simple and economic bio system using sugarcane straw. Int J Environ Agric Biotechnol 5:217–230. https://doi.org/10.22161/ijeab.51.31
Chen Y, Wu C, Fan X, Zhao X, Zhao X, Shen T, Wei D, Wang W (2020) Engineering of Trichoderma reesei for enhanced degradation of lignocellulosic biomass by truncation of the cellulase activator ACE3. Biotechnol Biofuels 13:62. https://doi.org/10.1186/s13068-020-01701-3
Cosgrove DJ (2014) Re-constructing our models of cellulose and primary cell wall assembly. Curr Opin Plant Biol 22:122–131. https://doi.org/10.1016/j.pbi.2014.11.001
Cunha FM, Kreke T, Badino AC, Farinas CS, Ximenes E, Ladisch MR (2014) Liquefaction of sugarcane bagasse for enzyme production. Bioresour Technol 172:249–252. https://doi.org/10.1016/j.biortech.2014.09.025
D’hooge E, Becker P, Stubbe D, Normand AC, Piarroux R, Hendrickx M (2019) Black aspergilli: a remaining challenge in fungal taxonomy? Med Mycol 57:773–780. https://doi.org/10.1093/mmy/myy124
Daher FB, Braybrook SA (2015) How to let go: pectin and plant cell adhesion. Front Plant Sci 57:6. https://doi.org/10.3389/fpls.2015.00523
Deshpande SK, Bhotmange MG, Chakrabarti T, Shastri PN (2008) Production of cellulase and xylanase by Trichoderma reesei (QM 9414 mutant), Aspergillus niger and mixed culture by solid state fermentation (SSF) of water hyacinth (Eichhornia crassipes). Indian J Chem Technol 15:449–456. https://doi.org/10.1016/j.jbiotec.2012.01.001
Dhillon GS, Oberoi HS, Kaur S, Bansal S, Brar SK (2011) Value-addition of agricultural wastes for augmented cellulase and xylanase production through solid-state tray fermentation employing mixed-culture of fungi. Ind Crops Prod 34:1160–1167. https://doi.org/10.1016/j.indcrop.2011.04.001
di Cologna N d M, Gómez-Mendoza DP, Zanoelo FF, Giannesi GC, Cavalieri NG, de Souza Moreira LR, Filho EXF, Ricart CAO (2018) Exploring Trichoderma and Aspergillus secretomes: proteomics approaches for the identification of enzymes of biotechnological interest. Enzyme Microb Technol 109:1–10. https://doi.org/10.1016/j.enzmictec.2017.08.007
Do Vale LHF, Filho EXF, Miller RNG, Ricart CAO, de Sousa MV (2014) Cellulase systems in Trichoderma: An overview. In: Gupta V, Schmoll M, Herrera-Estrella A, Upadhyay RS, Druzhinina I, Tuohy M (eds) Biotechnology and Biology of Trichoderma. Elsevier, pp 229–244.
Espiñeira JM, Novo Uzal E, Gómez Ros LV, Carrión JS, Merino F, Barceló AR, Pomar F (2011) Distribution of lignin monomers and the evolution of lignification among lower plants. Plant Biol 13:59–68. https://doi.org/10.1111/j.1438-8677.2010.00345.x
Fang H, Zhao C, Song XY, Chen M, Chang Z, Chu J (2013) Enhanced cellulolytic enzyme production by the synergism between Trichoderma reesei RUT-C30 and Aspergillus niger NL02 and by the addition of surfactants. Biotechnol Bioprocess Eng 18:390–398. https://doi.org/10.1007/s12257-012-0562-8
Fatma S, Saleem A, Tabassum R (2020) Wheat straw hydrolysis by using co-cultures of Trichoderma reesei and Monascus purpureus toward enhanced biodegradation of the lignocellulosic biomass in bioethanol biorefinery. Biomass Convers Biorefinery. https://doi.org/10.1007/s13399-020-00652-x
Florencio C, Cunha FM, Badino AC, Farinas CS, Ximenes E, Ladisch MR (2016) Secretome analysis of Trichoderma reesei and Aspergillus niger cultivated by submerged and sequential fermentation processes: enzyme production for sugarcane bagasse hydrolysis. Enzyme Microb Technol 90:53–60. https://doi.org/10.1016/j.enzmictec.2016.04.011
Grous W, Converse A, Grethlein H, Lynd L (1985) Kinetics of cellobiose hydrolysis using cellobiase composites from Trichoderma reesei and Aspergillus niger. Biotechnol Bioeng 27:463–470. https://doi.org/10.1002/bit.260270411
Gutiérrez-correa M, Villena GK (2012) Batch and repeated batch cellulase production by mixed cultures of Trichoderma reesei and Aspergillus niger or Aspergillus phoenicis. J Microbiol Biotechnol Res 2:929–935
Hiscox J, O’Leary J, Boddy L (2018) Fungus wars: basidiomycete battles in wood decay. Stud Mycol 89:117–124. https://doi.org/10.1016/j.simyco.2018.02.003
Hymery N, Vasseur V, Coton M, Mounier J, Jany JL, Barbier G, Coton E (2014) Filamentous fungi and mycotoxins in Cheese: a review. Compr Rev Food Sci Food Saf 13:437–456. https://doi.org/10.1111/1541-4337.12069
Igarashi Y, Li N, He B, Luo F, Zhong Z, Liu L (2018) Label-free differentially proteomic analysis of interspecific interaction between white-rot fungi highlights oxidative stress response and high metabolic activity. Fungal Biol 122:774–784. https://doi.org/10.1016/j.funbio.2018.04.005
Kolasa M, Ahring BK, Lübeck PS, Lübeck M (2014) Co-cultivation of Trichoderma reesei RutC30 with three black Aspergillus strains facilitates efficient hydrolysis of pretreated wheat straw and shows promises for on-site enzyme production. Bioresour Technol 169:143–148. https://doi.org/10.1016/j.biortech.2014.06.082
Kong W, Fu X, Wang L, Alhujaily A, Zhang J, Ma F, Zhang X, Yu H (2017) A novel and efficient fungal delignification strategy based on versatile peroxidase for lignocellulose bioconversion. Biotechnol Biofuels 10:218. https://doi.org/10.1186/s13068-017-0906-x
Kumar AK, Sharma S (2017) Recent updates on different methods of pretreatment of lignocellulosic feedstocks: a review. Bioresour Bioprocess 4:1–19. https://doi.org/10.1186/s40643-017-0137-9
Ma K, Ruan Z (2015) Production of a lignocellulolytic enzyme system for simultaneous bio-delignification and saccharification of corn stover employing co-culture of fungi. Bioresour Technol 175:586–593. https://doi.org/10.1016/j.biortech.2014.10.161
Maheshwari DK, Gohade S, Paul J, Varma A (1994) Paper-mill sludge as a potential source for cellulase production by Trichoderma reesei QM 9123 and Aspergillus niger using mixed cultivation. Carbohydr Polym 23:161–163. https://doi.org/10.1016/0144-8617(94)90098-1
Mali T, Kuuskeri J, Shah F, Lundell TK (2017) Interactions affect hyphal growth and enzyme profiles in combinations of coniferous wood-decaying fungi of Agaricomycetes. PLoS One 12:9. https://doi.org/10.1371/journal.pone.0185171
Moreira LRS, Filho EXF (2008) An overview of mannan structure and mannan-degrading enzyme systems. Appl Microbiol Biotechnol 79:165–178. https://doi.org/10.1007/s00253-008-1423-4
Okeke BC (2014) Cellulolytic and xylanolytic potential of high β-glucosidase-producing Trichoderma from decaying biomass. Appl Biochem Biotechnol 174:1581–1598. https://doi.org/10.1007/s12010-014-1121-x
Ottosson E, Nordén J, Dahlberg A, Edman M, Jönsson M, Larsson KH, Olsson J, Penttilä R, Stenlid J, Ovaskainen O (2014) Species associations during the succession of wood-inhabiting fungal communities. Fungal Ecol 11:17–28. https://doi.org/10.1016/j.funeco.2014.03.003
Papagianni M (2007) Advances in citric acid fermentation by Aspergillus niger: biochemical aspects, membrane transport and modeling. Biotechnol Adv 25:244–263. https://doi.org/10.1016/j.biotechadv.2007.01.002
Rabello GC, Pirota RDPB, Barros GOF, Farinas CS (2014) Simultaneous biosynthesis of biomass-degrading enzymes using co-cultivation of Aspergillus niger and Trichoderma reesei. Biocatal Biotransformation 32:236–243. https://doi.org/10.3109/10242422.2014.934362
Rana V, Eckard AD, Teller P, Ahring BK (2014) On-site enzymes produced from Trichoderma reesei RUT-C30 and Aspergillus saccharolyticus for hydrolysis of wet exploded corn stover and loblolly pine. Bioresour Technol 154:282–289. https://doi.org/10.1016/j.biortech.2013.12.059
Romsdahl J, Blachowicz A, Chiang AJ, Singh N, Stajich JE, Kalkum M, Venkateswaran K, Wang CCC (2018) Characterization of Aspergillus niger isolated from the International Space Station. mSystems 3:5. doi:https://doi.org/10.1128/msystems.00112-18
Scheller HV, Ulvskov P (2010) Hemicelluloses. Annu Rev Plant Biol 61:263–289. https://doi.org/10.1146/annurev-arplant-042809-112315
Siddiquee S (2014) Recent advancements on the role and analysis of volatile compounds (VOCs) from Trichoderma. In: Gupta V, Schmoll M, Herrera-Estrella A, Upadhyay RS, Druzhinina I, Tuohy M (eds) Biotechnology and Biology of Trichoderma. Elsevier, pp 139–175. doi:https://doi.org/10.1016/B978-0-444-59576-8.00011-4
Silva COG, Vaz RP, Filho EXF (2017) Bringing plant cell wall-degrading enzymes into the lignocellulosic biorefinery concept. Biofuels Bioprod Biorefining 12:277–289. https://doi.org/10.1002/bbb.1832
Sørensen A, Lübeck M, Lübeck PS, Ahring BK (2013) Fungal beta-glucosidases: a bottleneck in industrial use of lignocellulosic materials. Biomol 3:612–631. https://doi.org/10.3390/biom3030612
Sperandio GB, Filho EXF (2019) Fungal co-cultures in the lignocellulosic biorefinery context: a review. Int Biodeterior Biodegrad 142:109–123. https://doi.org/10.1016/j.ibiod.2019.05.014
Ujor VC, Adukwu EC, Okonkwo CC (2018) Fungal wars: the underlying molecular repertoires of combating mycelia. Fungal Biol 122:191–202. https://doi.org/10.1016/j.funbio.2018.01.001
van Munster JM, Daly P, Delmas S, Pullan ST, Blythe MJ, Malla S, Kokolski M, Noltorp ECM, Wennberg K, Fetherston R, Beniston R, Yu X, Dupree P, Archer DB (2014) The role of carbon starvation in the induction of enzymes that degrade plant-derived carbohydrates in Aspergillus niger. Fungal Genet Biol 72:34–47. https://doi.org/10.1016/j.fgb.2014.04.006
Yang R, Meng D, Hu X, Ni Y, Li Q (2013) Saccharification of pumpkin residues by coculturing of Trichoderma reesei RUT-C30 and Phanerochaete chrysosporium Burdsall with delayed inoculation timing. J Agric Food Chem 61:9192–9199. https://doi.org/10.1021/jf402199j
Zhao C, Deng L, Fang H (2018) Mixed culture of recombinant Trichoderma reesei and Aspergillus niger for cellulase production to increase the cellulose degrading capability. Biomass Bioenergy 112:93–98. https://doi.org/10.1016/j.biombioe.2018.03.001
Funding
This study was funded by the Brazilian National Council for Scientific and Technological Development (grant 303614/2017-0).
Author information
Authors and Affiliations
Contributions
EXFF and GBS revised the literature and wrote the manuscript. Both authors have read and approved the manuscript.
Corresponding author
Ethics declarations
Ethical statement
This article does not contain any studies with human participants or animals performed by any of the authors.
Conflict of interest
The authors declare no competing interests.
Additional information
Publisher’s note
Springer Nature remains neutral with regard to jurisdictional claims in published maps and institutional affiliations.
Rights and permissions
About this article
Cite this article
Sperandio, G.B., Filho, E.X.F. An overview of Trichoderma reesei co-cultures for the production of lignocellulolytic enzymes. Appl Microbiol Biotechnol 105, 3019–3025 (2021). https://doi.org/10.1007/s00253-021-11261-7
Received:
Revised:
Accepted:
Published:
Issue Date:
DOI: https://doi.org/10.1007/s00253-021-11261-7